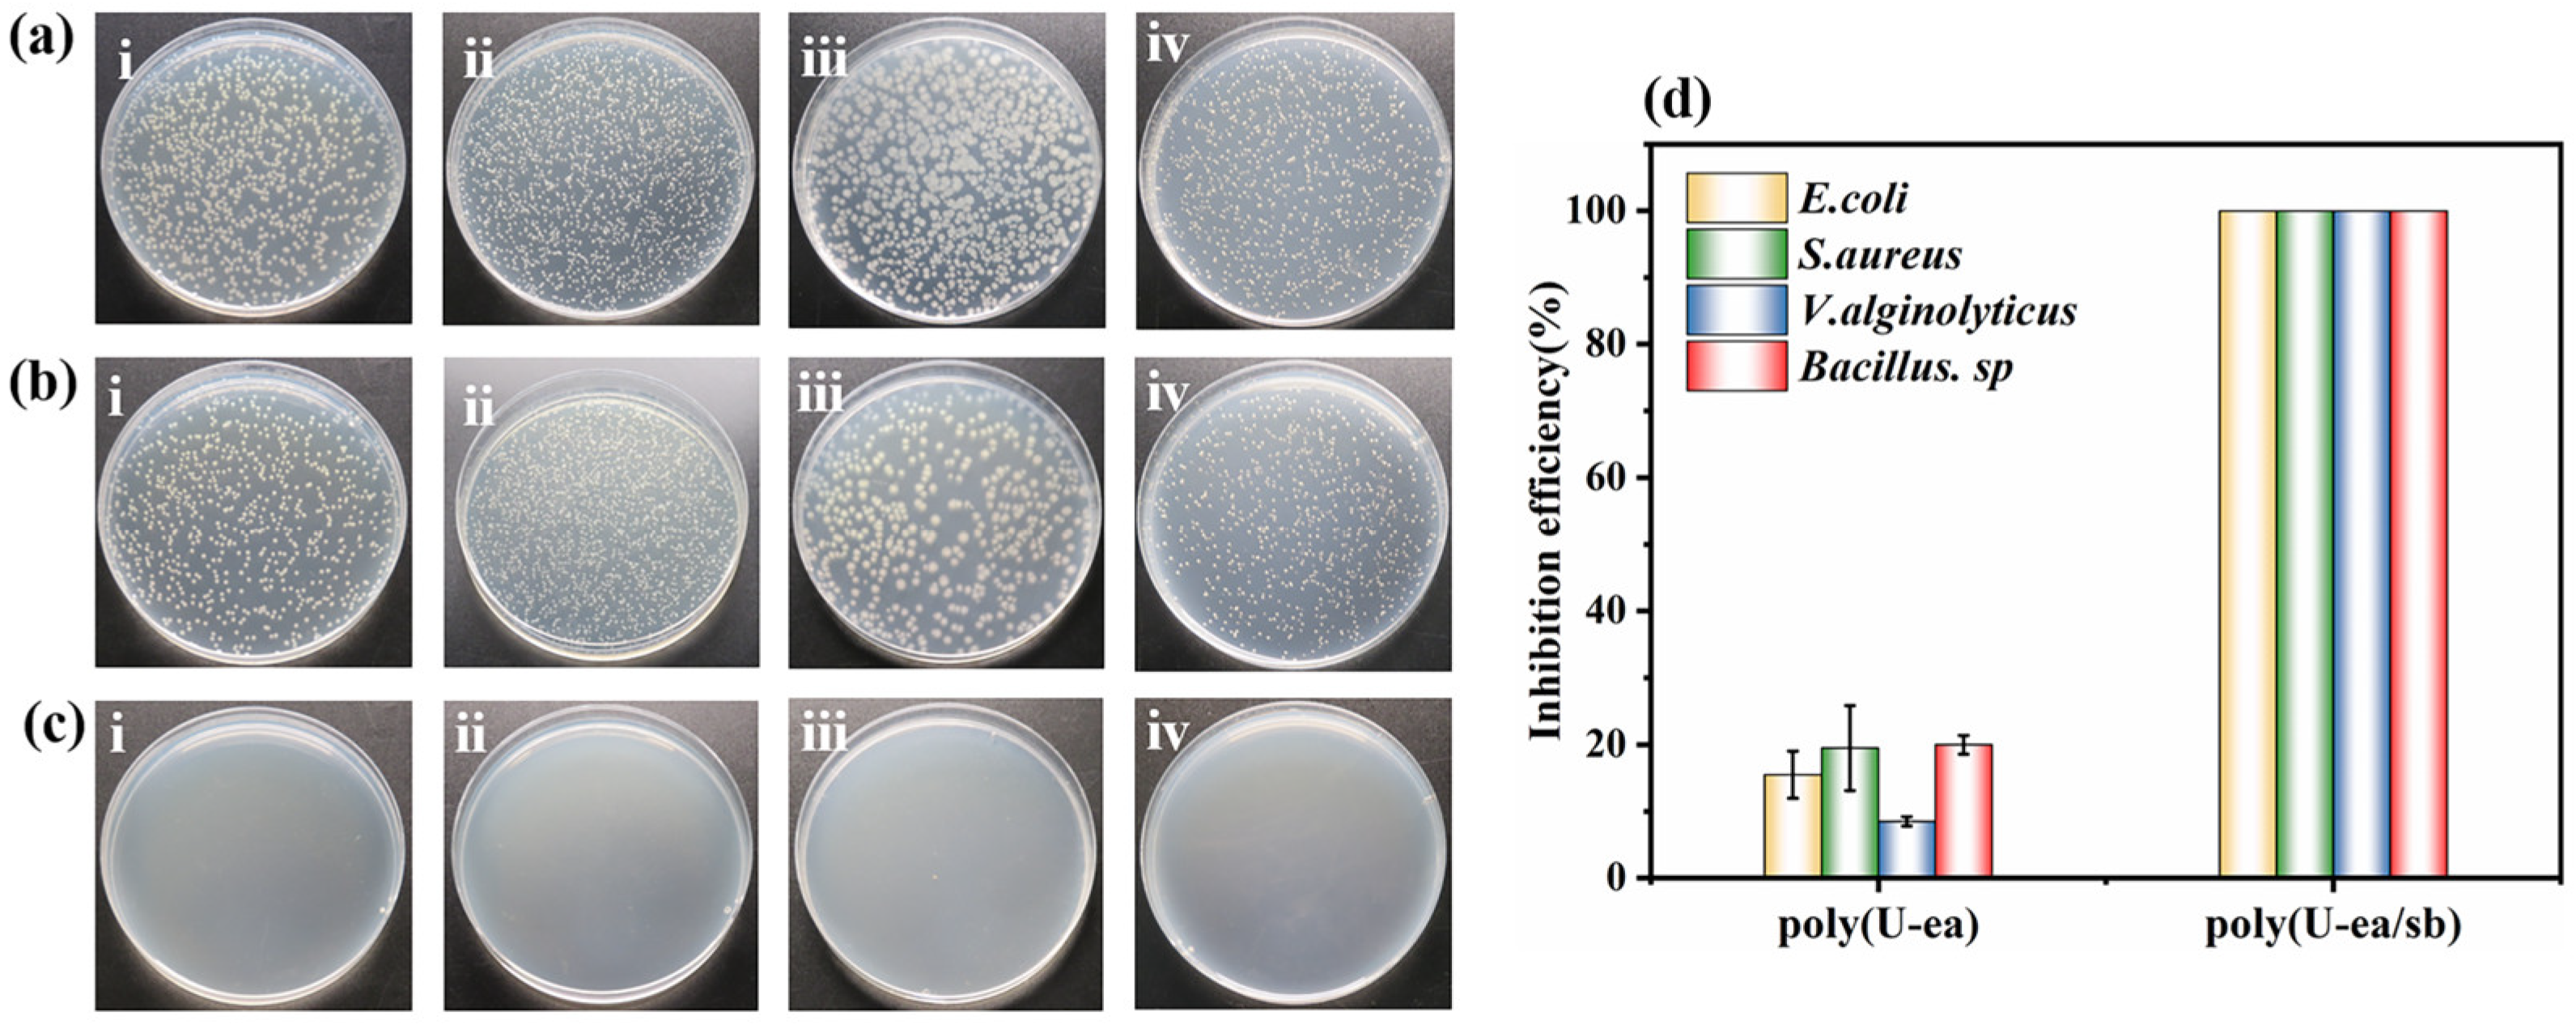
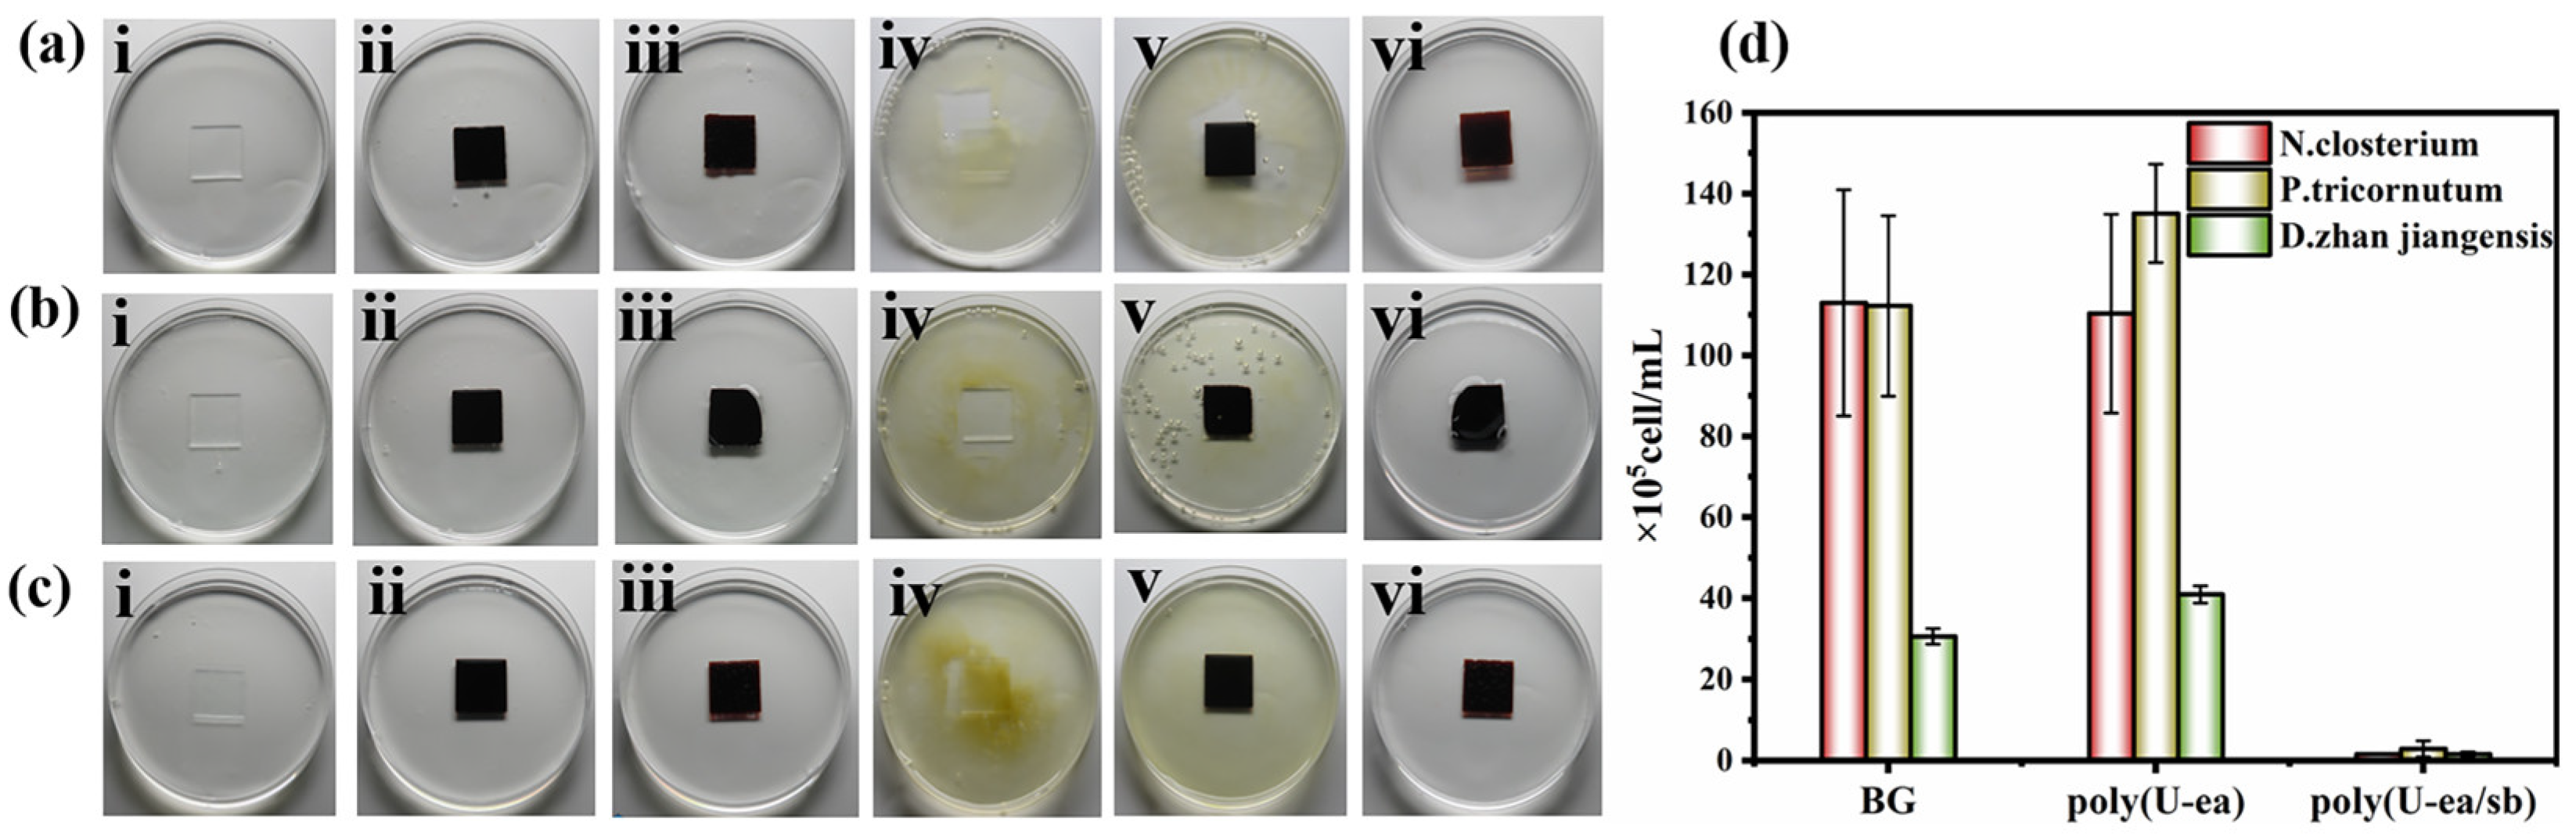

Urushiol-Based Benzoxazine Containing Sulfobetaine Groups for Sustainable Marine Antifouling Applications
Abstract
1. Introduction
2. Materials and Methods
2.1. Materials
2.2. Characterization
2.3. Synthesis of Urushiol-Based Benzoxazine Monomer (U−ea)
2.4. Introduction of Sulfobetaine Groups into Polybenzoxazine Chains
2.5. Fabrication of Poly(U−ea) and Poly(U−ea/sb) Coated Glass Slides and Tinplate Sheets
3. Results
3.1. Synthesis and Structural Characterization of U−ea and U−ea/sb
3.2. Surface Chemical Composition Analysis of Poly(U−ea/sb)
3.3. Properties of Poly(U−ea/sb)
3.4. Mechanical Properties of the Poly(U−ea/sb) Coatings
3.5. Antiprotein Adsorption Performance of the Poly(U−ea/sb) Coatings
3.6. Antibacterial Performance of Poly(U−ea/sb) Coatings
3.7. Algal Inhibition Performance of the Poly(U−ea/sb) Coatings
4. Conclusions
Supplementary Materials
Author Contributions
Funding
Institutional Review Board Statement
Informed Consent Statement
Data Availability Statement
Conflicts of Interest
References
- Jin, H.; Tian, L.; Bing, W.; Zhao, J.; Ren, L. Bioinspired marine antifouling coatings: Status, prospects, and future. Prog. Mater. Sci. 2022, 124, 100889. [Google Scholar] [CrossRef]
- Pistone, A.; Scolaro, C.; Visco, A. Mechanical Properties of Protective Coatings against Marine Fouling: A Review. Polymers 2021, 13, 173. [Google Scholar] [CrossRef] [PubMed]
- Mohd, M.H.; Zalaya, M.A.; Latheef, M.; Choi, H.S.; Rahman, M.A.A.; Kim, D.K. Ultimate bending capacity of aged fixed platform by considering the effect of marine fouling. Lat. Am. J. Solids Struct. 2019, 16, e182. [Google Scholar] [CrossRef]
- Filgueira, D.; Bolano, C.; Gouveia, S.; Moldes, D. Enzymatic Functionalization of Wood as an Antifouling Strategy against the Marine Bacterium Cobetia marina. Polymers 2021, 13, 3795. [Google Scholar] [CrossRef] [PubMed]
- Bagley, F.; Atlar, M.; Charles, A.; Anderson, C. The use of copper-based antifoulings on aluminium ship hulls. Ocean. Eng. 2015, 109, 595–602. [Google Scholar] [CrossRef]
- Watson, G.J.; Pini, J.M.; Richir, J. Chronic exposure to copper and zinc induces DNA damage in the polychaete Alitta virens and the implications for future toxicity of coastal sites. Environ. Pollut. 2018, 243, 1498–1508. [Google Scholar] [CrossRef]
- Amara, I.; Miled, W.; Slama, R.B.; Ladhari, N. Antifouling processes and toxicity effects of antifouling paints on marine environment. A review. Environ. Toxicol. Pharmacol. 2018, 57, 115–130. [Google Scholar] [CrossRef]
- Han, S.; Raknuzzaman, M.; Naito, W.; Masunaga, S. Assessment of Metal Levels in Sediments and Oyster (Crassostrea gigas) Tissues from Shidugawa Bay, a Closed Japanese Aquaculture Environment. Water Air Soil Pollut. 2020, 231, 341. [Google Scholar] [CrossRef]
- Gevaux, L.; Lejars, M.; Margaillan, A.; Briand, J.F.; Bunet, R.; Bressy, C. Hydrolyzable Additive-Based Silicone Elastomers: A New Approach for Antifouling Coatings. Polymers 2019, 11, 305. [Google Scholar] [CrossRef]
- Tong, Z.; Guo, H.; Di, Z.; Sheng, Y.; Song, L.; Hu, J.; Gao, X.; Hou, Y.; Zhan, X.; Zhang, Q. Squid inspired elastomer marine coating with efficient antifouling strategies: Hydrophilized defensive surface and lower modulus. Colloids Surf. B Biointerfaces 2022, 213, 112392. [Google Scholar] [CrossRef]
- Kim, S.; Ye, S.H.; Adamo, A.; Orizondo, R.A.; Jo, J.; Cho, S.K.; Wagner, W.R. A biostable, anti-fouling zwitterionic polyurethane-urea based on PDMS for use in blood-contacting medical devices. J. Mater. Chem. B 2020, 8, 8305–8314. [Google Scholar] [CrossRef]
- Zhou, L.; Wang, H.; Du, J.; Fu, J.; Wang, W. Synthesis of polysulfopropylbetaine and its application inantibacterial cotton fabric. J. Text. Res. 2019, 41, 84–90. [Google Scholar] [CrossRef]
- Shahkaramipour, N.; Jafari, A.; Tran, T.; Stafford, C.M.; Cheng, C.; Lin, H. Maximizing the grafting of zwitterions onto the surface of ultrafiltration membranes to improve antifouling properties. J. Membr. Sci. 2020, 601, 117909. [Google Scholar] [CrossRef]
- Ventura, C.; Guerin, A.J.; El-Zubir, O.; Ruiz−Sanchez, A.J.; Dixon, L.I.; Reynolds, K.J.; Dale, M.L.; Ferguson, J.; Houlton, A.; Horrocks, B.R.; et al. Marine antifouling performance of polymer coatings incorporating zwitterions. Biofouling 2017, 33, 892–903. [Google Scholar] [CrossRef]
- Anthony Yesudass, S.; Mohanty, S.; Nayak, S.K.; Rath, C.C. Zwitterionic–polyurethane coatings for non−Specific marine bacterial inhibition: A nontoxic approach for marine application. Eur. Polym. J. 2017, 96, 304–315. [Google Scholar] [CrossRef]
- Nikam, S.P.; Chen, P.; Nettleton, K.; Hsu, Y.H.; Becker, M.L. Zwitterion Surface-Functionalized Thermoplastic Polyurethane for Antifouling Catheter Applications. Biomacromolecules 2020, 21, 2714–2725. [Google Scholar] [CrossRef]
- Cao, Z.; Mi, L.; Mendiola, J.; Ella-Menye, J.R.; Zhang, L.; Xue, H.; Jiang, S. Reversibly switching the function of a surface between attacking and defending against bacteria. Angew. Chem. Int. Ed. Engl. 2012, 51, 2602–2605. [Google Scholar] [CrossRef]
- Chiang, Y.-C.; Chang, Y.; Higuchi, A.; Chen, W.-Y.; Ruaan, R.-C. Sulfobetaine-grafted poly(vinylidene fluoride) ultrafiltration membranes exhibit excellent antifouling property. J. Membr. Sci. 2009, 339, 151–159. [Google Scholar] [CrossRef]
- Hibbs, M.R.; Hernandez−Sanchez, B.A.; Daniels, J.; Stafslien, S.J. Polysulfone and polyacrylate-based zwitterionic coatings for the prevention and easy removal of marine biofouling. Biofouling 2015, 31, 613–624. [Google Scholar] [CrossRef]
- Liu, H.; Ma, Z.; Yang, W.; Pei, X.; Zhou, F. Facile preparation of structured zwitterionic polymer substrate via sub−Surface initiated atom transfer radical polymerization and its synergistic marine antifouling investigation. Eur. Polym. J. 2019, 112, 146–152. [Google Scholar] [CrossRef]
- Quintana, R.; Janczewski, D.; Vasantha, V.A.; Jana, S.; Lee, S.S.; Parra-Velandia, F.J.; Guo, S.; Parthiban, A.; Teo, S.L.; Vancso, G.J. Sulfobetaine-based polymer brushes in marine environment: Is there an effect of the polymerizable group on the antifouling performance? Colloids Surf. B Biointerfaces 2014, 120, 118–124. [Google Scholar] [CrossRef] [PubMed]
- Zheng, L.; Sundaram, H.S.; Wei, Z.; Li, C.; Yuan, Z. Applications of zwitterionic polymers. React. Funct. Polym. 2017, 118, 51–61. [Google Scholar] [CrossRef]
- Lu, R.; Yoshida, T.; Miyakoshi, T. Oriental Lacquer: A Natural Polymer. Polym. Rev. 2013, 53, 153–191. [Google Scholar] [CrossRef]
- Lu, R.; Harigaya, S.; Ishimura, T.; Nagase, K.; Miyakoshi, T. Development of a fast drying lacquer based on raw lacquer sap. Prog. Org. Coat. 2004, 51, 238–243. [Google Scholar] [CrossRef]
- Chen, J.; Jian, R.; Yang, K.; Bai, W.; Huang, C.; Lin, Y.; Zheng, B.; Wei, F.; Lin, Q.; Xu, Y. Urushiol-based benzoxazine copper polymer with low surface energy, strong substrate adhesion and antibacterial for marine antifouling application. J. Clean. Prod. 2021, 318, 128527. [Google Scholar] [CrossRef]
- Luan, X.; Wang, B.; Yang, P.; Gu, Y. Enhancing the performances of polybenzoxazines by modulating hydrogen bonds. J. Polym. Res. 2019, 26, 85. [Google Scholar] [CrossRef]
- Zhang, K.; Liu, Y.; Han, M.; Froimowicz, P. Smart and sustainable design of latent catalyst-containing benzoxazine-bio-resins and application studies. Green Chem. 2020, 22, 1209–1219. [Google Scholar] [CrossRef]
- Chen, Q.; Zhang, L.; Zhang, J.; Habib, S.; Lu, G.; Dai, J.; Liu, X. Bio-based polybenzoxazines coatings for efficient marine antifouling. Prog. Org. Coat. 2023, 174, 107298. [Google Scholar] [CrossRef]
- Xu, H.; Lu, Z.; Zhang, G. Synthesis and properties of thermosetting resin based on urushiol. RSC Adv. 2012, 2, 2768–2772. [Google Scholar] [CrossRef]
- Chen, Y. Drug-to-antibody ratio (DAR) by UV/Vis spectroscopy. Methods Mol. Biol. 2013, 1045, 267–273. [Google Scholar] [CrossRef]
- Duncombe, T.A.; Ponti, A.; Seebeck, F.P.; Dittrich, P.S. UV-Vis Spectra-Activated Droplet Sorting for Label-Free Chemical Identification and Collection of Droplets. Anal. Chem. 2021, 93, 13008–13013. [Google Scholar] [CrossRef]
- Suhartono, E.; Thalib, I.; Aflanie, I.; Noor, Z.; Idroes, R. Study of Interaction between Cadmium and Bovine Serum Albumin with UV-Vis Spectrocopy Approach. IOP Conf. Ser. Mater. Sci. Eng. 2018, 350, 012008. [Google Scholar] [CrossRef]
- Kacprzynska-Golacka, J.; Kowalik-Klimczak, A.; Woskowicz, E.; Wiecinski, P.; Lozynska, M.; Sowa, S.; Barszcz, W.; Kazmierczak, B. Microfiltration Membranes Modified with Silver Oxide by Plasma Treatment. Membranes 2020, 10, 133. [Google Scholar] [CrossRef]
- Zhang, T.; Gu, J.; Liu, X.; Wei, D.; Zhou, H.; Xiao, H.; Zhang, Z.; Yu, H.; Chen, S. Bactericidal and antifouling electrospun PVA nanofibers modified with a quaternary ammonium salt and zwitterionic sulfopropylbetaine. Mater. Sci Eng. C Mater. Biol. Appl. 2020, 111, 110855. [Google Scholar] [CrossRef]
- Yang, C.; Ding, X.; Ono, R.J.; Lee, H.; Hsu, L.Y.; Tong, Y.W.; Hedrick, J.; Yang, Y.Y. Brush-Like Polycarbonates Containing Dopamine, Cations, and PEG Providing a Broad−Spectrum, Antibacterial, and Antifouling Surface via One−Step Coating. Adv. Mater. 2014, 26, 7346–7351. [Google Scholar] [CrossRef]
- Kacprzynska-Golacka, J.; Kowalik-Klimczak, A.; Skowronski, J.; Rajewska, P.; Wiecinski, P.; Smolik, J. Possibilities of using plasma techniques of surface engineering for modification of polymer membranes. Polimery 2018, 63, 353–361. [Google Scholar] [CrossRef]
- Kowalik-Klimczak, A.; Stanislawek, E. Reclamation of water from dairy wastewater using polymeric nanofiltration membranes. Desalination Water Treat. 2018, 128, 364–371. [Google Scholar] [CrossRef]
- Sztuk−Sikorska, E.; Gradon, L. Biofouling reduction for improvement of depth water filtration. Filter Prod. Test. Chem. Process. Eng. 2016, 37, 319–330. [Google Scholar] [CrossRef]
- Kowalik-Klimczak, A.; Stanislawek, E.; Kacprzynska-Golacka, J.; Bednarska, A.; Osuch−Slomka, E.; Skowronski, J. The polyamide membranes functionalized by nanoparticles for biofouling control. Desalination Water Treat. 2018, 128, 243–252. [Google Scholar] [CrossRef]
- Kacprzynska-Golacka, J.; Lozynska, M.; Barszcz, W.; Sowa, S.; Wiecinski, P.; Woskowicz, E. Microfiltration Membranes Modified with Composition of Titanium Oxide and Silver Oxide by Magnetron Sputtering. Polymers 2020, 13, 141. [Google Scholar] [CrossRef]
- Hao, X.; Wang, W.; Yang, Z.; Yue, L.; Sun, H.; Wang, H.; Guo, Z.; Cheng, F.; Chen, S. pH responsive antifouling and antibacterial multilayer films with Self-healing performance. Chem. Eng. J. 2019, 356, 130–141. [Google Scholar] [CrossRef]
- Lu, G.; Tian, S.; Li, J.; Xu, Y.; Liu, S.; Pu, J. Fabrication of bio-based amphiphilic hydrogel coating with excellent antifouling and mechanical properties. Chem. Eng. J. 2021, 409, 128134. [Google Scholar] [CrossRef]
- Deng, Y.; Song, G.-L.; Zheng, D.; Zhang, Y. Fabrication and synergistic antibacterial and antifouling effect of an organic/inorganic hybrid coating embedded with nanocomposite Ag@TA−SiO particles. Colloids Surf. A Physicochem. Eng. Asp. 2021, 613, 126085. [Google Scholar] [CrossRef]
- Wang, D.; Xu, J.; Yang, J.; Zhou, S. Preparation and synergistic antifouling effect of self-renewable coatings containing quaternary ammonium-functionalized SiO2 nanoparticles. J. Colloid Interface Sci. 2020, 563, 261–271. [Google Scholar] [CrossRef] [PubMed]
- Sathya, S.; Murthy, P.S.; Das, A.; Gomathi Sankar, G.; Venkatnarayanan, S.; Pandian, R.; Sathyaseelan, V.S.; Pandiyan, V.; Doble, M.; Venugopalan, V.P. Marine antifouling property of PMMA nanocomposite films: Results of laboratory and field assessment. Int. Biodeterior. Biodegrad. 2016, 114, 57–66. [Google Scholar] [CrossRef]
- Jiang, T.; Qi, L.; Qin, W. Improving the Environmental Compatibility of Marine Sensors by Surface Functionalization with Graphene Oxide. Anal. Chem. 2019, 91, 13268–13274. [Google Scholar] [CrossRef]
- Sha, J.; Chen, R.; Yu, J.; Liu, Q.; Liu, J.; Zhu, J.; Liu, P.; Li, R.; Wang, J. Dynamic multi-level microstructured antifouling surfaces by combining quaternary ammonium modified GO with self-polishing copolymers. Carbon 2023, 201, 1038–1047. [Google Scholar] [CrossRef]
- Song, F.; Wang, J.; Zhang, L.; Chen, R.; Liu, Q.; Liu, J.; Yu, J.; Liu, P.; Duan, J. Synergistically Improved Antifouling Efficiency of a Bioinspired Self-renewing Interface via a Borneol/Boron Acrylate Polymer. J. Colloid Interface Sci. 2022, 612, 459–466. [Google Scholar] [CrossRef]

| Samples | Adhesion Strength (MPa) | Pencil Hardness | Glossiness (%) |
|---|---|---|---|
| poly(U−ea) | 0.28 | 8H | 97.9 |
| poly(U−ea/sb) | 0.56 | 5H | 66.1 |
Disclaimer/Publisher’s Note: The statements, opinions and data contained in all publications are solely those of the individual author(s) and contributor(s) and not of MDPI and/or the editor(s). MDPI and/or the editor(s) disclaim responsibility for any injury to people or property resulting from any ideas, methods, instructions or products referred to in the content. |
© 2023 by the authors. Licensee MDPI, Basel, Switzerland. This article is an open access article distributed under the terms and conditions of the Creative Commons Attribution (CC BY) license (https://creativecommons.org/licenses/by/4.0/).
Share and Cite
Zhao, J.; Chen, J.; Zheng, X.; Lin, Q.; Zheng, G.; Xu, Y.; Lin, F. Urushiol-Based Benzoxazine Containing Sulfobetaine Groups for Sustainable Marine Antifouling Applications. Polymers 2023, 15, 2383. https://doi.org/10.3390/polym15102383
Zhao J, Chen J, Zheng X, Lin Q, Zheng G, Xu Y, Lin F. Urushiol-Based Benzoxazine Containing Sulfobetaine Groups for Sustainable Marine Antifouling Applications. Polymers. 2023; 15(10):2383. https://doi.org/10.3390/polym15102383
Chicago/Turabian StyleZhao, Jing, Jipeng Chen, Xiaoxiao Zheng, Qi Lin, Guocai Zheng, Yanlian Xu, and Fengcai Lin. 2023. "Urushiol-Based Benzoxazine Containing Sulfobetaine Groups for Sustainable Marine Antifouling Applications" Polymers 15, no. 10: 2383. https://doi.org/10.3390/polym15102383
APA StyleZhao, J., Chen, J., Zheng, X., Lin, Q., Zheng, G., Xu, Y., & Lin, F. (2023). Urushiol-Based Benzoxazine Containing Sulfobetaine Groups for Sustainable Marine Antifouling Applications. Polymers, 15(10), 2383. https://doi.org/10.3390/polym15102383
